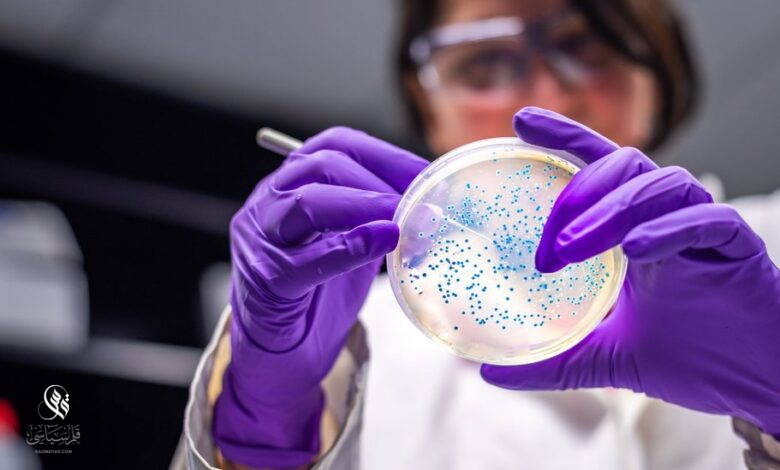

منظمة الصحة: استعدوا لوباء أشد فتكاً من كوفيد-19
أكد رئيس منظمة الصحة العالمية أنه يجب على العالم أن يكون مستعدا للاستجابة لتفشي مرض” أكثر فتكا” من كوفيد-19.
وفي خطاب ألقاه أمام جمعية الصحة العالمية في جنيف، حذر المدير العام لمنظمة الصحة العالمية تيدروس أدهانوم غيبريسوس من أن نهاية كوفيد-19 كحالة طوارئ صحية عالمية لا تعني أن تهديد الصحة العالمي قد انتهى.
وقال في اجتماع صنع القرار السنوي للدول الأعضاء في منظمة الصحة العالمية البالغ عددها 194 دولة: “خطر ظهور متغير آخر يتسبب في اندلاع موجات جديدة من المرض والوفاة لا يزال قائما”.”والتهديد من مرض آخر ينشأ مع إمكانية أن يكون أكثر فتكا لا يزال محتملا”.
وجاءت تصريحات تيدروس خلال إعلان منظمة الصحة العالمية عن إطلاق شبكة دولية لمراقبة مسببات الأمراض، للمساعدة في تحديد التهديدات الناشئة عن الأمراض والاستجابة لها باستخدام علم الجينوم.
ويمكن للمعلومات الجينية من الفيروسات والبكتيريا والكائنات الحية الأخرى المسببة للأمراض أن تساعد العلماء في التعرف على الأمراض وتتبعها وتطوير العلاجات واللقاحات.
وقال تيدروس في حفل الإطلاق إن الشبكة تهدف إلى منح كل دولة إمكانية الوصول إلى التسلسل الجيني الممرض والتحليلات كجزء من نظام الصحة العامة الخاص بها.





